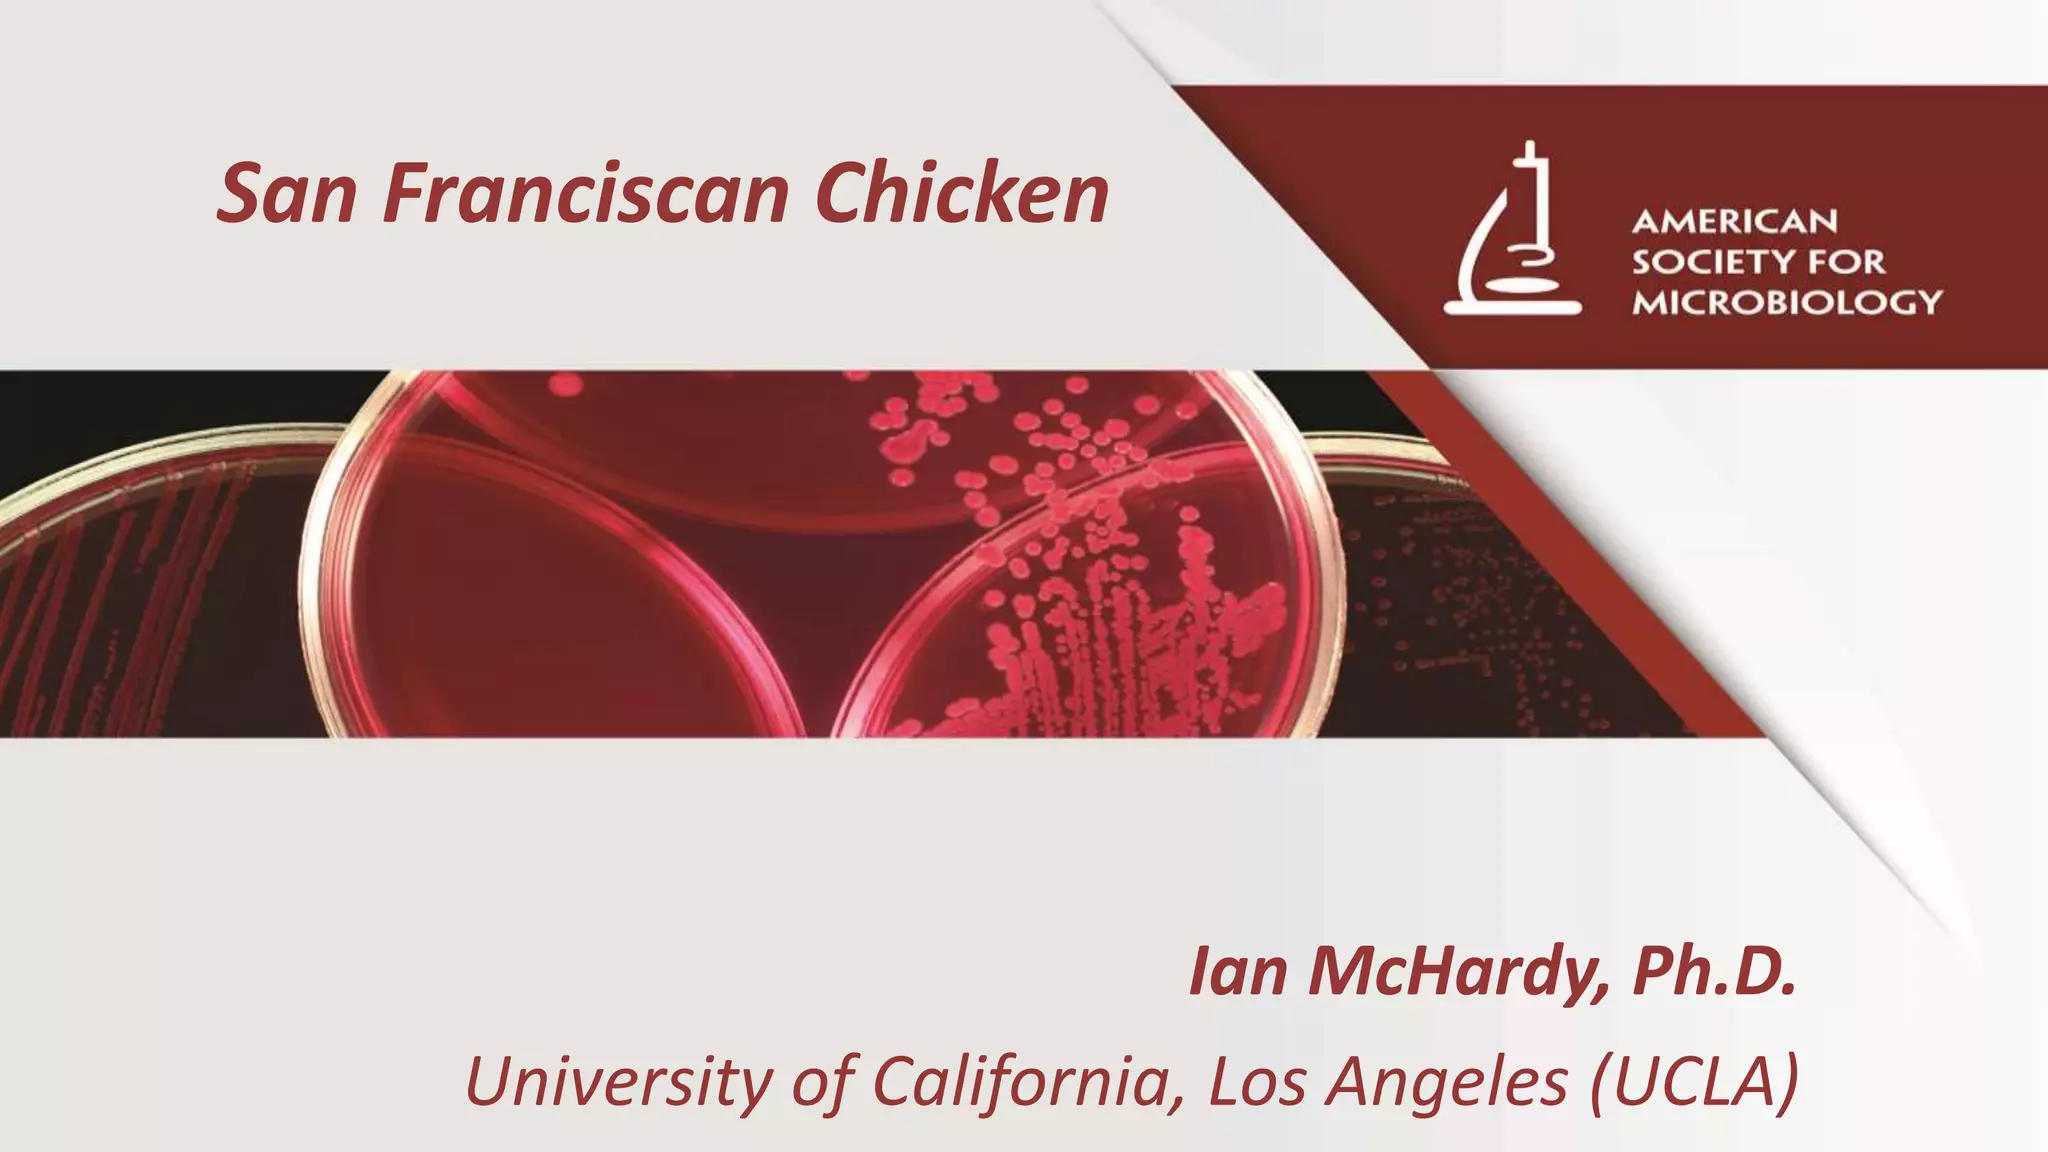

A 2-year old male presented with fever and diarrhea. Stool culture identified Salmonella enterica serotype Heidelberg, matching an outbreak linked to chicken. This led to antibiotic treatment and recovery, altering the patient's care. Salmonella is classified into two species, with S. enterica having over 2500 serotypes commonly transmitted by food like chicken. Identification and antibiotic guidance helps manage high-risk cases and limit resistance.